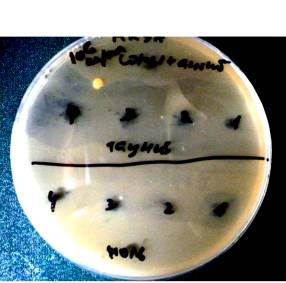
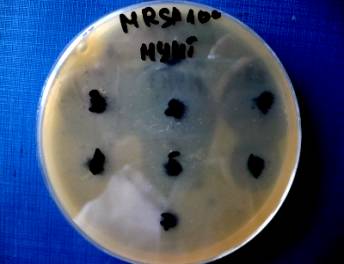

Медицина/12. Инфекционные болезни (Инфектология).
Тимофеева А.В.3, Галатенко О.А.1, Ильина М.В.2, Терехова Л.П.1, Катруха Г.С.1
1 ФГБУ НИИ по
изысканию новых антибиотиков им. Г.Ф. Гаузе РАМН,
г. Москва,
Россия.
2Российский
химико-технологический университет им. Д.И. Менделеева,
г. Москва,
Россия.
3НИИ
ФХБ им. А.Н.Белозерского, МГУ, г. Москва, Россия
Получение и исследование
антимикробной активности комплексов типа «антибиотик-нанотрубки»
(«Таунит»-антибиотик).
В настоящее время инфекционные заболевания
продолжают оставаться одной из наиболее серьезных проблем здравоохранения во
всем мире. Бесконтрольная и не всегда целесообразная терапия антибиотиками
привела к развитию множественной лекарственной резистентности бактерий к
антимикробным препаратам. Решить эту проблему пытаются как путем поиска новых
природных антибиотиков, так и с помощью химической модификации известных
антибиотиков и синтеза новых синтетических лекарственных средств. Однако, на
сегодняшний день известно, что даже новые, современные препараты не могут
полностью устранить резистентность бактериальных патогенов к антибиотикам.
Попытки увеличивать дозу назначаемых антибиотиков приводят к увеличению
токсичности и, как следствие, к развитию побочных эффектов у больных.
Выход из создавшейся ситуации возможен
при целенаправленной разработке и создании новых, эффективных препаратов,
которыми, в частности, могут стать «наноантибиотики» - наноматериалы,
предназначенные для борьбы с инфекционными заболеваниями. Такие наноматериалы
проявляют антимикробную активность либо самостоятельно, либо, если материал
неактивен, в комплексе с антимикробным агентом (антибиотиком) [1].
В настоящей
работе в качестве наноматериала для создания «наноантибиотика» мы решили использовать многостенные нанотрубы (МУНТ)
типа «Таунит» [2] (Рис.1). Сами нанотрубы типа «Таунит» не обладают ни
антимикробной, ни антифунгальной активностью и поэтому мы считаем, что «Таунит»
целесообразно применять для борьбы с патогенной микрофлорой в виде комплексов с
антибиотиками. Для работы были выбраны известные и практически важные антибиотики:
гризеовиридин и этамицин А (активные в отношении Staphylococcus aureus (MRSA), полимиксин В (активный в отношении Escherichia сoli) и нистатин,
обладающий высокой активностью в отношении микромицетов и, в частности, Aspergillus niger [3].

Рис.1 Электронная сканирующая микроскопия многостенных
углеродных нанотруб типа «Таунит» [2]. Репер в правом нижнем углу имеет размер
1 мкм.
Иммобилизацию антибиотиков на «Таунит»
проводили в статических условиях путем добавления к навеске (5,0 мг) сорбента
«Таунит» 600 мкл водного раствора антибиотиков с концентрацией 0,2 мг/мл.
Антибиотики гризеовиридин и этамицин А смешивали в массовом соотношении 1:1, в
результате концентрация каждого антибиотика в растворе равнялась 0,2 мг/мл. Суспензии «Таунит»-антибиотик выдерживали в течение 18 час. при
18-200С. По окончании сорбции раствор антибиотика отделяли от
сорбента центрифугированием на микроцентрифуге фирмы BECKMAN COULTER ™ Microfuge®
18 Centrifuge (США) в течение 5-7 мин. при 11894g. Количество антибиотиков в
растворе до сорбции и после сорбции определяли методом обращеннофазовой
высокоэффективной жидкостной хроматографии (ОФ ВЭЖХ) на микроколоночном хроматографе Милихром А-02”(ЗАО «Эконова», г.
Новосибирск, Россия) [4] с колонками из нержавеющей стали размером
(2.0×75,0 мм), заполненными сорбентом Nucleosil 100-5C18 РАН фирмы «Macherey-Nagel»
(Германия). Колонки термостатированы при 35°С. Реагенты готовили, используя воду высшей степени очистки
(18.1 Мом/см), полученную на установке Milli-Q®Plus «Millipore» (Франция); ацетонитрил для
ВЭЖХ фирмы «Sigma-Aldrich» (Германия). Для анализа готовили растворы
антибиотиков в воде с концентрацией 0,2 – 3,0 мг/мл. Объем вводимой пробы
составлял 5-15 мкл. Детекцию разделяемых веществ осуществляли при двух длинах
волн - 214 и 280 нм. Время ОФ ВЭЖХ анализа - 25 мин. для каждого из
анализируемых препаратов антибиотиков. В работе использовали линейный градиент
подвижной фазы, создаваемый элюентом А (0.1% раствор трифторуксусной кислот
(ТФУ) в воде) и элюентом В (0.1% раствор ТФУ в ацетонитриле). Полученные
хроматограммы оценивали с помощью компьютерной программы МультиХром–СПЕКТР для
Windows 9х &NT версия 1,5х-Е («Амперсенд», Россия).
В ходе исследования было установлено, что
в разработанных нами условиях выбранные антибиотики этамицин А, гризеовиридин,
полимиксин В и нистатин полностью адсорбируются на «Тауните», образуя прочные
комплексы [5]. При испытании полученных комплексов в
опытах in vitro методом биоавтографии на агаровых пластинах [6],
содержащих чувствительные к указанным антибиотикам тест-организмы, было
установлено, что комплексы «Таунит»-(гризеовиридин+этамицин А) высоко активны в отношении метициллин-резистентного Staphylococcus aureus (MRSA); комплекс «Таунит»-нистатин проявляет антифунгальную активность
в отношении Aspergillus niger, а комплекс «Таунит»-полимиксин В
практически не подавляет рост Escherichia сoli (таблица 1).
Таблица
1. Антибактериальная активность комплексов «Таунит»-антибиотик.
|
№п/п |
Комплекс |
Тест-организм |
Антибактериальная/антифугаль-ная активность комплекса
(диаметр зоны подавления роста, мм) |
|
1 |
«Таунит»-(гризеовиридин+этамицин А) |
Staphylococcus aureus (MRSA) |
30±0.2 |
|
2 |
«Таунит»-полимиксин В |
Escherichia сoli |
нет активности |
|
3 |
«Таунит»-нистатин |
Aspergillus niger |
14±0.2 |
Возможно, что отсутствие антимикробной
активности у комплекса «Таунит»-полимиксин В связано с тем, что
полимиксины воздействуют на
цитоплазматическую мембрану бактериальной клетки (в нашем случае Escherichia сoli), взаимодействуя с фосфолипидами мембраны. Они связываются
посредством NH2-групп, входящих
в состав молекулы полимиксина В с анионными участками мембраны, конкретно, с
остатками карбоксильных групп и, таким образом,
повреждают структуру мембраны. В результате происходит изменения проницаемости
мембраны как для внутри-, так и для внеклеточных компонентов, что вызывает
гибель клетки [7]. Мы предполагаем, что адсорбция полимиксина В на нанотрубы
проходит, в том числе, и посредством взаимодействия NH2-групп
антибиотика с остатками СООH-групп,
расположенных на поверхности (торцах) трубок [8]. NH2-группы
антибиотика, оказавшись связанными прочными ионными связями с СООH-группами нанотруб, не могут вступить во взаимодействие с
анионными участками клеточной мембраны, и поэтому комплекс «Таунит»- полимиксин
В оказывается неактивным.
Для комплексов «Таунит»-(грзеовиридин+этамицин
А), обладающих высокой антимикробной активностью в отношении MRSA, было проведено изучение их антимикробной активности при
различной количественной нагрузке «Таунита» антибиотиками. Из литературных
данных известно, что такие исследования проводят путем сравнения активности
комплекса с активностью «чистого» антибиотика, используя метод лунок [9]. Нам представляется такое сравнение не совсем корректным,
поскольку сравниваются разные (по агрегатному состоянию) смеси, а именно, гомогенный раствор «чистого» антибиотика с
гетерогенной суспензией комплекса сорбент–антибиотик. Поэтому мы проводили
исследования, сравнивая антимикробную активность комплексов «Таунит»-антибиотик
с комплексами антибиотик-активированный уголь (АУ) полученными
в результате иммобилизации антибиотиков на известный уголь - Darco G-60, particle size
18µm (USA). Для этого на 5 мг сорбентов («Таунита» и АУ) была
иммобилизована смесь антибиотиков (гризеовиридин+этамицин А) в следующих
количествах: точка 1 на чашке Петри – 120 мкг+120 мкг, точка 2 – 60 мкг+60 мкг,
точка 3 – 30 мкг+30 мкг, точка 4. – 15 мкг+15 мкг (методику см. выше). Полноту
сорбции определяли с помощью ОФ-ВЭЖХ анализа по методике, представленной выше.
Было установлено, что при любой количественной нагрузке антибиотики полностью
адсорбируются как на «Таунит», так и на АУ. Результаты антимикробной активности
полученных комплексов представлены на рис. 3, и таблице 2. Из рисунка и таблицы следует, что
антимикробная активность комплекса «Таунит»-(гризеовиридин+этамицин А)
значительно выше, чем активность
комплекса АУ-(гризеовиридин+этамицин А). Так, например, при
использовании комплексов с максимальным количеством иммобилизованных
антибиотиков (120+120 мкг, соответственно) диаметр зоны подавления роста у
комплекса «Таунит»- (гризеовиридин+этамицин А) равен 30±0,2 мм, а у АУ -
(гризеовиридин+этамицин А) - 13±0,2 мм.
При нагрузке сорбентов антибиотиками в количестве 15 мкг+15 мкг,
соответственно, диаметр зоны подавления роста у комплекса
«Таунит»-(гризеовиридин+этамицин А) - 30±0,2 мм, а для комплекса
АУ-(гризеовиридин+этамицин А) – следы (ободок). Поэтому для «Таунита» были проведены опыты по иммобилизации на
сорбент еще меньших количеств антибиотиков, а именно точка 5 - 7,5 мкг+7,5 мкг, точка 6 - 3,75 мкг+3,75 мкг, точка 7
-1,87 мкг+1,87 мкг (см. рис.4 Таблица 2). Полученные
результаты свидетельствуют о том, что даже при адсорбции минимального
количества антибиотиков на «Таунит» (1,87 мкг+1,87 мкг), комплекс «Таунит»-(гризеовиридин+этамицин
А) проявляет антимикробную активность в отношении MRSA (диаметр зоны роста 9±0,2 мм) (см. рис. 4, Таблица
2), тогда как комплекс АУ - (гризеовиридин+этамицин А) практически неактивен
уже при нагрузке на АУ антибиотиками в количестве (15 мкг+15 мкг) (см. рис.3,
Таблица 2).
Рис.3
Антимикробная активность комплексов «Таунит»-(гризеовиридин+этамицин
А) и АУ-(гризеовиридин+этамицин А) в отношении S. aureus
(MRSA) при разной количественной нагрузке
антибиотиков на сорбент. Верх (над чертой): комплексы «Таунит»-антибиотики. Низ (под чертой): комплексы АУ-антибиотики (на рисунке точки 1-4 расположены справа налево)
Таблица 2. Антимикробная активность комплекса «Таунит»-(гризеовиридин+этамицин
А) и АУ-(гризеовиридин+этамицин А) в зависимости от количества иммобилизованных
антибиотиков на «Тауните».
|
№п/п |
Количество
антибиотиков (гризеовиридина+этамицина А), иммобилизованных на «Таунит» и АУ, мкг |
Антимикробная
активность комплексов в отношении Staphylococcus aureus (MRSA) |
|
|
«Таунит»-
гризеовиридин +этамицин
А |
АУ-гризеовиридин +этамицин
А |
||
|
Диаметр
зоны подавления роста, мм |
|||
|
1. |
120+120 |
30±0,2 |
13±0,2 |
|
2. |
60+60 |
30±0,2 |
11±0,2 |
|
3. |
30+30 |
30±0,2 |
7-9±0,2 |
|
4. |
15+15 |
30±0,2 |
Обод (н/а) |
|
5. |
7,5+7,5 |
20±0,2 |
- |
|
6. |
3,75+3,75 |
12±0,2 |
- |
|
7. |
1,87+1,87 |
9±0,2 |
- |
Рис.4
Антимикробная активность комплексов «Таунит»- (гризеоиридин+этамицин
А) в отношении S. aureus (MRSA) с различной количественной нагрузкой антибиотиков на трубы.
(на рисунке в верхнем ряду справа налево расположены точки 1-3, в среднем - точки 4-6, в нижнем - точка 7).
Для интерпретации полученных
результатов мы предлагаем следующие объяснение. Ранее нами опытным путем было
показано, что антибиотики гризеовиридин и этамицин А образуют очень прочный
комплекс с твердой матрицей «Таунита» [5].
Вероятно поэтому сами антибиотики не могут диффундировать в агар, а
диффузия осуществляется путем (за счет)
проникновения целиком комплекса
«Таунит»-антибиотик через микропоры, существующие в агаре, и именно этот
комплекс вызывает подавление роста тест-организма на
агаровом блоке. Возможно, по такому же принципу проявляет антимикробную
активность комплекс АУ-антибиотик, но поскольку размер частиц сорбента «Таунит»
меньше (40 нм), чем размер частиц АУ (18 µm), комплексу АУ-антибиотик
сложнее диффундировать в агар. Поэтому антибактериальная активность комплексов
«Таунит»- антибиотик существенно больше, чем комплексов АУ- антибиотик. Мы
также предполагаем, что антимикробная активность комплексов зависит как от
способа иммобилизации антибиотика на сорбент, так и от размера и формы
поверхности сорбента-носителя. В работе
мы использовали «Таунит» в форме «матрешка» [10] (рис.5), на которую, как
известно, антибиотики адсорбируются на поверхности материала [2]. В то же время иммобилизация веществ на АУ
проходит, в основном, посредством проникновения в глубь пор, имеющихся в
огромных количествах у активированных углей [11]. Поэтому антибиотик, иммобилизованный
на «Тауните», может достаточно свободно контактировать с клеточной стенкой
бактерией, а сорбированный на АУ - становится недоступным для взаимодействия
(контакта) с бактериальной клеткой.

Рис.5 Многостенные углеродные нанотрубы в форме «матрешка»
Результаты проведенного
исследования дают основание для более детального исследования антифугальной
активности полученных комплексов «Таунит»-нистатин как в отношении A. niger, так и других штаммов низших грибов; поиска
антибиотиков, которые в комплексе с «Таунитом» смогут проявлять высокую
антимикробную активность в отношении E. сoli, а также более
широкого исследования комплексов «Таунита» с другими известными и практически
важными антибиотиками, чтобы, в перспективе, использовать комплексы типа
«Таунит»-антибиотик в клинической практике в качестве «наноантибиотиков».
Литература:
1. Ae Jung Huh ,
Young Jik Kwon “Nanoantibiotics”: A new paradigm for
treating infectious diseases using nanomaterials in the antibiotics resistant
era. J. of Controlled Release.- 2011.- V.156- PP. 128–145
2.
Мищенко С.В. Углеродные наноматериалы. Производство, свойства, применение.
/Мищенко С.В., А.Г. Ткачев. // М. Машиностроение. – 2008. – № 2. – С. 17 – 21.
3. The Merck Index. An encyclopedia of chemicals, drugs, and biological. Tenth edition. Martha Windholz, Editor. Published by Merck & Co., Inc. Rahway, N.Y., U.S.A., 1983
4. ЭкоНова: HI-TECH в
аналитическом приборостроении. // Technopolis XXI.- 2005.-№ 2 (www.econova.ru).
5.
Тимофеева А.В. Исследования процессов сорбции и десорбции антибиотиков разных
групп на многослойных углеродных нанотрубках типа «Таунит». /Тимофеева А.В.,
Ильина М.В., Сапурина И.Ю., Баратова Л.А., Катруха Г.С. // IX
Международная научно-практическая конференция «Современные научные
достижения-2013» 27.01.2013-05.02.2013г. (статья будет напечатана в сборнике Publishing House «Education and
Science»
s.r.o (Czech Republic, Prague))
6. Haese A.
Genetics of Actinomycin C Production in Streptomyces chrysomallus. Haese A., Keller U. // J. Bacteriol.-
1988. - V. 170 (3).- P. 1360-1368.
7.
Щетинин Е.В. Полимиксины - новый взгляд на известные антибиотики. //
Клиническая микробиология и антимикробная химиотерапия. -2000.- Т.2.-№3-
с.68-72.
8.
Раков Э.Г. Химия и применение углеродных нанотрубок // Успехи химии. – 2001. –
Т. 70, № 10. – С. 939
9.
G. L. Burygin, B. N. Khlebtsov , A. N. Shantrokha , L. A. Dykman, V. A. Bogatyrev , N. G. Khlebtsov. On the Enhanced Antibacterial Activity of Antibiotics
Mixed with Gold Nanoparticles // Nanoscale Res. Lett. -2009. – V. 4. PP. 794–801.
10.
Еременко А.С. Исследование углеродных волокон и углеродных нанотрубок. /
Еременко А.С., Власов А.И. // Двенадцатая научная конференция «Шаг в будущее-
Москва, 2009» Доклады на тематической секции кафедры ИУ4 МГТУ им. Н.Э Баумана.–
2009. (IU4.BMSTU.RU)
11.
Водоподготовка: справочник (Под редакцией Беликова С.Е. М: Аква-Терм. -2007.-С.
240.